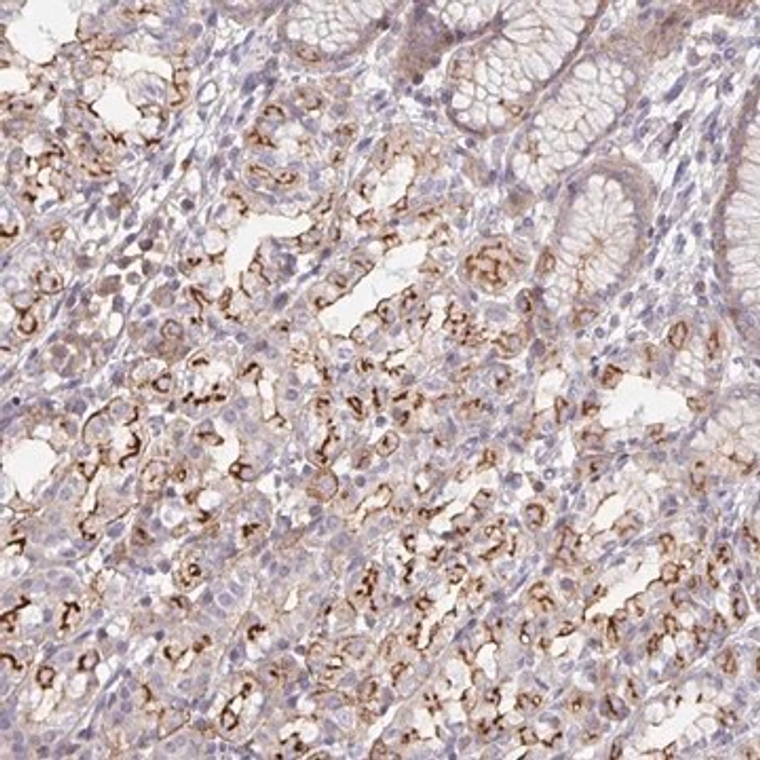
Anti-DISP2 antibody produced in rabbit, 1 X 100 µL (HPA059903-100UL)

Bulk Discount Available!

Anti-DISP2 antibody produced in rabbit, 1 X 100 µL (HPA059903-100UL)
MilliporeSigma® (Sigma-Aldrich)
$668.35
Earn points on this purchase